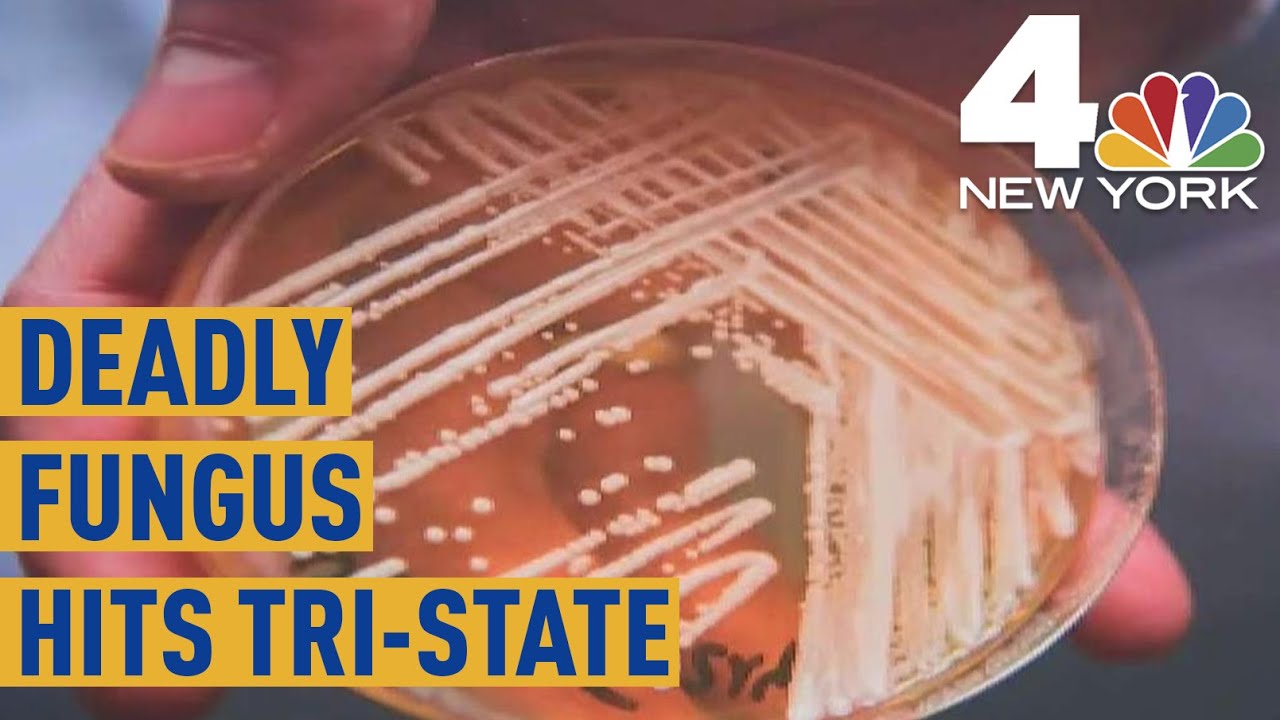
Drug-Resistant Superbug Candida Auris Spreading in New York | NBC New York

Candida auris: Hospitals mobilize to fight the deadly infection скачать в хорошем качестве
Повторяем попытку...

Скачать видео с ютуб по ссылке или смотреть без блокировок на сайте: Candida auris: Hospitals mobilize to fight the deadly infection в качестве 4k
У нас вы можете посмотреть бесплатно Candida auris: Hospitals mobilize to fight the deadly infection или скачать в максимальном доступном качестве, видео которое было загружено на ютуб. Для загрузки выберите вариант из формы ниже:
-
Информация по загрузке:
Скачать mp3 с ютуба отдельным файлом. Бесплатный рингтон Candida auris: Hospitals mobilize to fight the deadly infection в формате MP3:
Если кнопки скачивания не
загрузились
НАЖМИТЕ ЗДЕСЬ или обновите страницу
Если возникают проблемы со скачиванием видео, пожалуйста напишите в поддержку по адресу внизу
страницы.
Спасибо за использование сервиса ClipSaver.ru
Candida auris: Hospitals mobilize to fight the deadly infection
A highly contagious fungal infection that may not respond to medication could put hospital and nursing home patients at risk. The CDC says Candida auris has been detected on six continents since it was first identified a decade ago. There are 715 confirmed or suspected cases in the U.S. Meg Oliver reports. Watch "CBS This Morning" HERE: http://bit.ly/1T88yAR Download the CBS News app on iOS HERE: https://apple.co/1tRNnUy Download the CBS News app on Android HERE: https://bit.ly/1IcphuX Like "CBS This Morning" on Facebook HERE: http://on.fb.me/1LhtdvI Follow "CBS This Morning" on Twitter HERE: http://bit.ly/1Xj5W3p Follow "CBS This Morning" on Instagram HERE: http://bit.ly/1Q7NGnY Get new episodes of shows you love across devices the next day, stream local news live, and watch full seasons of CBS fan favorites anytime, anywhere with CBS All Access. Try it free! http://bit.ly/1OQA29B Each weekday morning, "CBS This Morning" co-hosts Gayle King, Anthony Mason and Tony Dokoupil deliver two hours of original reporting, breaking news and top-level newsmaker interviews in an engaging and informative format that challenges the norm in network morning news programs. The broadcast has earned a prestigious Peabody Award, a Polk Award, four News & Documentary Emmys, three Daytime Emmys and the 2017 Edward R. Murrow Award for Best Newscast. The broadcast was also honored with an Alfred I. duPont-Columbia Award as part of CBS News division-wide coverage of the shootings at Sandy Hook Elementary School in Newtown, Connecticut. Check local listings for "CBS This Morning" broadcast times.